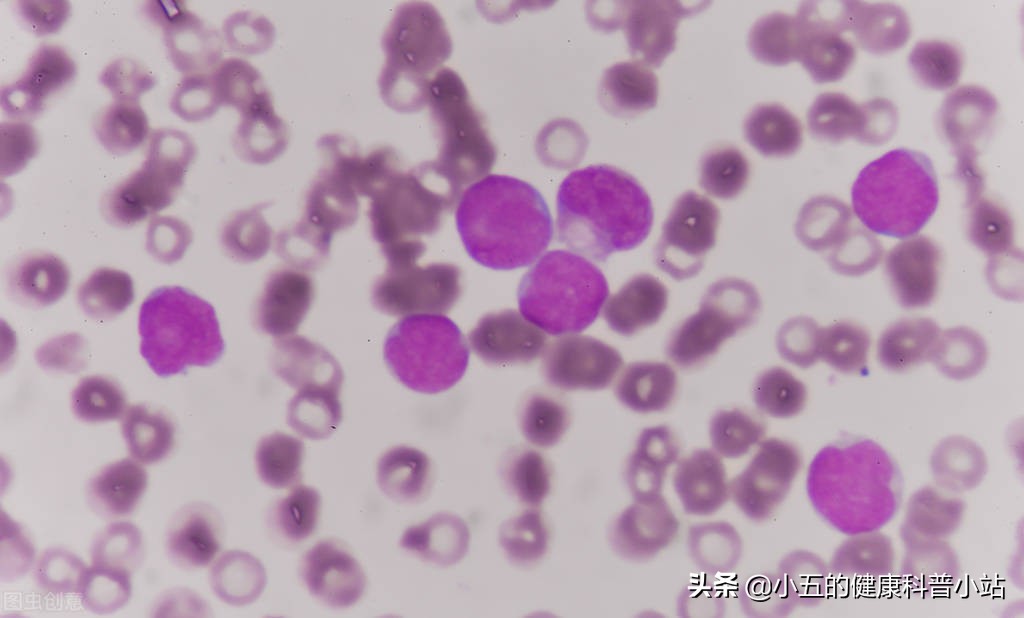
老年人白细胞2.6多无任何症状,老年人白细胞增高怎么降得快点

白细胞减少症是许多老年人常见的一种疾病,临床多表现为身体中的中性粒细胞、淋巴细胞数量下降,同时伴有机体免疫功能不足,导致经常出现细菌或者病毒感染,严重影响老年人的身体健康和生活质量,有些老年人认为这是机体衰老的正常反应,其实这是不对的,面对白细胞减少症,我们应该积极进行纠正和治疗,从而有效防治多种感染性疾病,今天就给大家介绍5种可以提升白细胞的常用药物。
70岁的张奶奶近半年发现自己免疫力明显下降,时不时就因为肺部感染、泌尿系感染等原因需要住院治疗。在1次住院过程中, 医生发现张奶奶的白细胞严重偏低,只有1.71×10 9 /L ,远低于正常水平,经过仔细询问后发现原来半年前张奶奶做过甲状腺部分切除手术,术后白细胞的水平就莫名其妙的降低了,张奶奶一直以为是年纪大了导致的,所以一直也没有在意。 但医生告诉张奶奶这其实是一种疾病,叫做白细胞减少症,正是由于白细胞的数量减少,所以导致她的免疫力明显下降,非常容易感染疾病,而半年前的甲状腺手术就是诱因,并且给张奶奶开具了可以提升白细胞的药物,通过一段时间的科学治疗,张奶奶的白细胞数量很快提升上来了,免疫力也逐渐好转 。

白细胞减少症是一种由于多种原因造成血液中白细胞数量明显降低的血压系统疾病,患者常因为白细胞数量的明显减少,从而导致机体免疫力明显下降,导致容易继发细菌或者病毒感染,同时也可以伴有 头晕、乏力,肢体酸软,食欲减退 等一系列临床症状, 特别是老年人多见,尤其是既往进行过手术或者放化疗的老年人常合并有不同程度的白细胞减少,导致反复出现感染性疾病,严重时甚至威胁生命健康,因此及时发现和纠正白细胞水平对于维护老年人的身体健康尤为重要 。
一、白细胞减少症的发病机制
白细胞是人体重要的血细胞之一,其与红细胞、血小板和血浆共同组成了人体的血液。白细胞是由中性粒细胞、淋巴细胞、巨噬细胞、单核细胞等多种免疫细胞组成,是人体免疫系统的重要组成部分, 当病原体进入血液后,白细胞可以通过吞噬或者产生抗体的方式将入侵的病原体消灭,从而起到防御和保护人体健康的目的 。正常成年人的白细胞数量约在 4-10×10 9 /L, 只有在白细胞数量正常的基础上,人体的免疫系统才能充分发挥作用,但如果有诱因导致白细胞的数量 少于4×10 9 /L,则会明显导致机体免疫力下降 ,临床上将这种情况称为白细胞减少症。

临床上造成白细胞减少的原因很多,按照不同的发病机制可以分为以下4类:
①多种诱因导致白细胞生产减少
白细胞是由骨髓中的造血干细胞增殖而来,而一旦骨髓造血干细胞损伤则会继发性地导致白细胞生成减少,常见的的诱因包括部分 血液系统疾病(如再生障碍性贫血等)、放化疗、药物因素(如秋水仙碱等) 等,这些因素会 影响造血干细胞的分化和成熟障,从而导致白细胞的数量减少 。
②多种诱因导致白细胞破坏过多
正常情况下人体中白细胞的生成和消耗是处于动态平衡的, 但如果白细胞消耗数量远超过生成数量,则会导致白细胞数量不平衡,诱发白细胞减少症 ,常见的原因包括 病毒感染、甲状腺炎、系统性红斑狼疮、脾大 等,这些因素都会对白细胞产生破坏作用,导致白细胞数量下降。
③多种诱因导致白细胞分布异常
这种情况常见于白细胞的患者, 由于白细胞的异常增殖,结果导致边缘池中白细胞增多,进而导致血液中白细胞减少 ,导致继发性的白细胞减少症。
④多种诱因导致白细胞成熟异常
造血干细胞从分裂分化再到成熟成为白细胞需要经过数个环节,这个过程成为白细胞成熟环节, 在这个环节中需要多种微量元素的支持,如叶酸、维生素B12等,一旦发生营养缺乏这会导致白细胞的成熟过程受阻,导致白细胞生成减少 。
二、哪些人群容易诱发白细胞减少症?
1、老年人
老年人由于其骨髓造血功能逐渐衰退,同时容易合并多种既往疾病,因此非常容易出现白细胞生成不足,导致诱发白细胞减少症 ,这也是为什么老年人往往存在免疫力低下的重要原因,因此对于老年人而言,一旦出现白细胞减少则需要及时进行纠正,从而降低诱发感染性疾病的风险。

2、接受化疗的肿瘤人群
放疗和化疗是肿瘤患者常用的治疗手段,但这2种方式都 会对骨髓的造血干细胞产生破坏作用,从而导致骨髓造血功能下降 , 诱发白细胞减少、贫血、血小板减少等多种血细胞数量的下降,因此针对肿瘤患者而言,及时纠正白细胞的减少状态对于提高机体免疫力,减轻放化疗的副作用具有重要意义 。

3、免疫系统疾病或者血液系统疾病
许多免疫系统疾病会对白细胞造成破坏,从而诱发白细胞减少,如 系统性红斑狼疮、甲状腺炎、类风湿性关节炎 等;其次, 再生障碍性贫血、白血病 等血液系统疾病对于白细胞的生成和分布也有影响,临床上也可以见到白细胞减少。
4、消化道手术或者营养不良的人群
接受过消化道手术(如胃切除、肠道切除等)的患者对于营养物质的吸收和消化具有明显障碍, 导致维生素B12、叶酸、蛋白质等多种营养物质吸收减少 ,从而导致白细胞成熟环节受阻,影响白细胞的生成。
三、科学服用5种药物提升白细胞数量
发现白细胞减少后,我们除了要尽量避免诱发因素外,还要通过科学的治疗来提升白细胞数量,改善机体的免疫功能, 临床上我们经常采用以下5种药物来治疗白细胞减少症 。
1、鲨肝醇

鲨肝醇是一种从鲨鱼鱼肝油中分离取得的促进白细胞增生药,临床常用于治疗应放化疗、药物中毒等原因导致的白细胞减少症。 药理学研究表明鲨肝醇是一种骨髓造血组织中含有的造血因子,对于促进造血干细胞的增殖和分化具有显著的效果,可以促进白细胞的增殖 ,同时可以抵抗放化疗或者具有细胞毒性的药物对于造血系统的抑制作用,并且本药安全性较好,适合老年人和儿童使用。 但需要注意的是长期口服鲨肝醇会引起腹泻、腹痛等胃肠道反应,但大多数停药后可以缓解,其次服药期间要定期监测血常规,白细胞水平恢复正常后即可暂停用药 。
2、利可君

利可君是一种半胱氨酸的衍生物,药理学研究表明口服利可君后,其可以在肠道内与蛋白结合,从而被肠道迅速吸收, 从而加强骨髓造血干细胞的增殖,促进白细胞的生成 ,临床常用于治疗多种原因造成的白细胞减少,也可以用于治疗再生障碍性贫血。 但需要注意的是白血病患者禁用利可君,容易加重病情;其次,口服利可君会出现消化系统反应,如口干、腹痛、食欲减退等;最后,利可君需要避光保存,否则容易挥发 。
3、磷酸腺嘌呤片
磷酸腺嘌呤是核酸前体,同时也是核酸的重要组成部分, 通过补充磷酸腺嘌呤,可以促进RNA 、DNA的合成,从而促进多种血细胞的增殖 ,临床上常用于治疗多种原因导致的白细胞减少症,特别是对放化疗导致的白细胞减少具有明显效果。 常规剂量下磷酸腺嘌呤片的不良反应较少,但服用时间不宜过长,一般1-3个月即可;其次,磷酸腺嘌呤对于肿瘤细胞的繁殖也有促进作用,因此要考虑是否有促进肿瘤发展的可能,尽量在配合放化疗时使用 。
4、地榆升白片

地榆升白片是一种中药制剂,其主要的成分就是中药地榆,药 理学研究表明地榆可以保护人体的造血系统,促进造血干细胞的增殖和分化,提升外周血液中白细胞、血小板的数量,同时可以改善骨髓的微循环状态,调节和改善机体的免疫功能 ,临床上常用于治疗多种原因导致的白细胞减少症。 但需要注意的是长期口服地榆升白片会造成消化系统不良反应,导致胃痛、腹部疼痛等,其次,少数患者对于药物过敏,因此会出现皮疹、瘙痒等过敏反应 。
5、维生素B12和叶酸


叶酸和维生素B12都是白细胞成熟过程中不可缺少的营养物质,通过补充叶酸和维生素B12,可以有效促进白细胞的分化和增殖,特别是对于核酸的合成具有明显促进作用,因此常作为治疗贫血、白细胞减少症等血液系统疾病的药物。 但需要注意的是不可过度服用维生素B12和叶酸,因为过度服用维生素B12会造成肢体麻木、震颤等神经系统损害,也会诱发腹胀、食欲减退、恶心等胃肠道反应;其次,大量服用叶酸会导致尿液呈现黄色,并且造成肝肾功能异常,因此在补充维生素B12和叶酸时一定要注意剂量和服用时间 。
四、总结
一旦发现白细胞减少,应积极进行药物干预,从而可以提升白细胞数量,改善免疫功能,预防多种感染性疾病,但是不同患者所需要的用药方案不同,因此建议有需要的患者在专科医师的指导下用药。其次,药物治疗仅仅是改善白细胞减少的一种方法,患有白细胞减少的人还应该从饮食入手,不偏食、不挑食,营养均衡,特别是重视对于维生素和矿物质的摄取,适度运动,提高免疫力,从而为进一步改善造血系统的功能打下基
#心健康信科普#